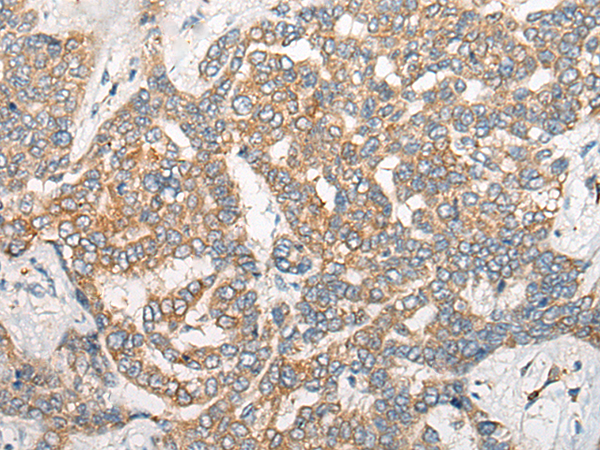
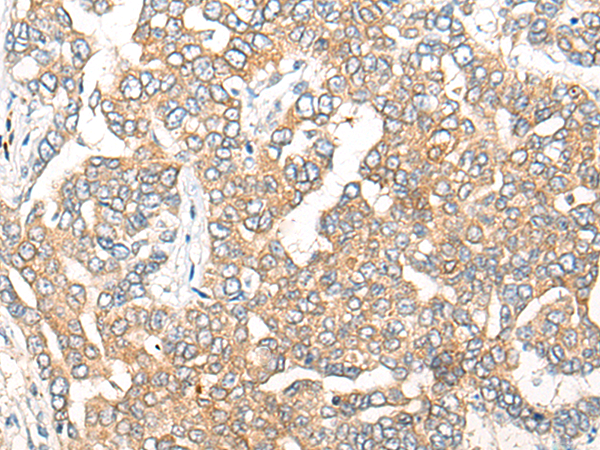

-
分类: 科研抗体货号: P13189别名: GAIP; RGSGAIP应用: IHC反应种属: Human, Mouse, Rat
-
分类: 科研抗体货号: P13209别名: FCC1; COCA1; HNPCC; LCFS2; HNPCC1应用: WB,IHC反应种属: Human, Mouse
-
分类: 科研抗体货号: P13188别名: GES; GD:REM应用: IHC反应种属: Human
-
分类: 科研抗体货号: P13192别名: PIP1; PTOP; TPP1; TINT1应用: WB反应种属: Human, Mouse, Rat
-
分类: 科研抗体货号: P13206别名:应用: IHC反应种属: Human, Mouse, Rat
-
分类: 科研抗体货号: P13187别名: RC; GNL; SMP30; HEL-S-41应用: WB,IHC反应种属: Human, Mouse, Rat
-
分类: 科研抗体货号: P13191别名: HET; ITM; BWR1A; IMPT1; TSSC5; ORCTL2; BWSCR1A; SLC22A1L; p45-BWR1A应用: IHC反应种属: Human
-
分类: 科研抗体货号: P13205别名: GY2; FKSG1; WDR14; WDVCF; DGCRK3应用: IHC反应种属: Human, Mouse
-
分类: 科研抗体货号: P13215别名: CPSF100应用: IHC反应种属: Human, Mouse
-
分类: 科研抗体货号: P13204别名: p54; ETS-1; EWSR2; c-ets-1应用: IHC反应种属: Human, Mouse, Rat

鄂公网安备42018502007531号
鄂公网安备42018502007531号

